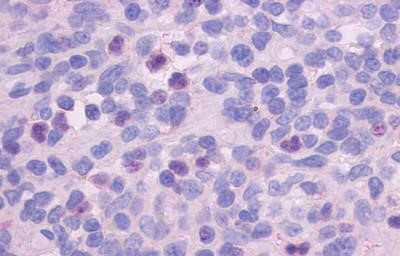
FPR1 Antibody in Immunohistochemistry (Paraffin) (IHC (P))

Search
Invitrogen
FPR1 Polyclonal Antibody
{{$productOrderCtrl.translations['antibody.pdp.commerceCard.promotion.promotions']}}
{{$productOrderCtrl.translations['antibody.pdp.commerceCard.promotion.viewpromo']}}
{{$productOrderCtrl.translations['antibody.pdp.commerceCard.promotion.promocode']}}: {{promo.promoCode}} {{promo.promoTitle}} {{promo.promoDescription}}. {{$productOrderCtrl.translations['antibody.pdp.commerceCard.promotion.learnmore']}}

Please note: We are reviewing Western blot images included in the antibody testing data in our catalog, including those provided by third parties. Unless expressly labeled or annotated as “raw-unedited”, Western blot images included in the antibody testing data in our catalog may have been edited, optimized or otherwise adjusted for presentation.
产品信息
PA5-33534
种属反应
已发表种属
宿主/亚型
分类
类型
抗原
偶联物
形式
浓度
规格
纯化类型
保存液
内含物
保存条件
运输条件
RRID
产品详细信息
Percent identity with other species by BLAST analysis: Human, Chimpanzee, Monkey (100%) Gorilla (94%) Orangutan (88%).
靶标信息
FPR1 is a member of chemoattractant/chemokine GPCRs expressed mainly on leukocytes, neutrophils and monocytes. FPR1 is a seven transmembrane pertussis toxin-sensitive GPCR and binds to formylated peptides generated by bacteria resulting in leukocyte trafficking to the site of inflammation. Ligand binding to FPR results in activation of multiple effectors including phospholipase C leading to calcium mobilization and PKC activation. Other implications of FPR signaling include polarization of actin cytoskeleton, activation of various integrins, increased cell migration, phagocytosis, degranulation and release of reactive oxygen intermediates.
仅用于科研。不用于诊断过程。未经明确授权不得转售。
生物信息学
蛋白别名: fMet-Leu-Phe receptor; fMLP receptor; Fpr receptor; FPR-1; N-formyl peptide receptor 1; N-formylpeptide chemoattractant receptor
基因别名: FPR1
Entrez Gene ID: (Human) 2357